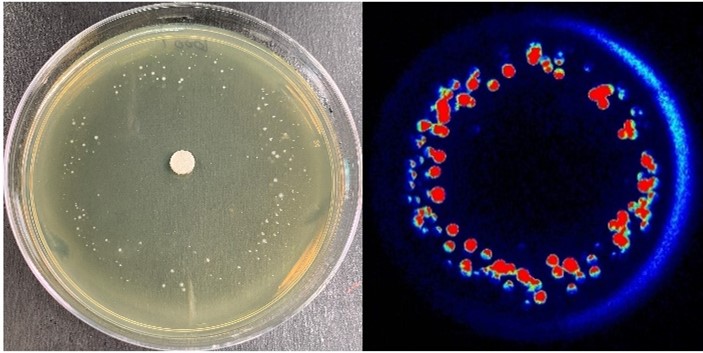

Quiz: Antibiotic Resistance and Researchers Studying It
Antibiotics are a class of drugs that treat bacterial infections. They may seem common now, but they were discovered less than a century ago. In 1928, Alexander Fleming, a scientist studying bacteria, found that mold from his bread kept bacteria from growing. He determined that “mold juice” was able to kill different types of harmful bacteria, and he and his assistants worked to figure out what natural product in the mold was actually causing the killing. It turned out to be penicillin!
Thanks to Fleming’s discovery, doctors have been successfully treating bacterial infections with penicillin and other newer antibiotics. But in recent years, some infections that were once treatable with antibiotics no longer respond to them. Some of these infections can be treated with multiple rounds of different antibiotic treatments, but others aren’t treatable at all—even leading to death in some cases.
The quiz below will test your knowledge of bacterial infections with examples from some of the scientists we’ve recently featured on the blog who explore new ways to fight these infections. Access the original blog posts at the bottom of the quiz to learn more about each of the researchers and their work.
From MARC Student to MacArthur Fellow (Dr. Victor Torres)
How Bacteria-Infecting Viruses Could Save Lives (Dr. Ryland Young)
Career Conversations: Q&A with Organic Chemist Elizabeth Parkinson
Career Conversations: Q&A with Bioengineer César de la Fuente

This post is a great supplement to Pathways: The Superbug Issue.
Both this post and Pathways discuss antibiotic resistance.
Learn more in our Educator's Corner.